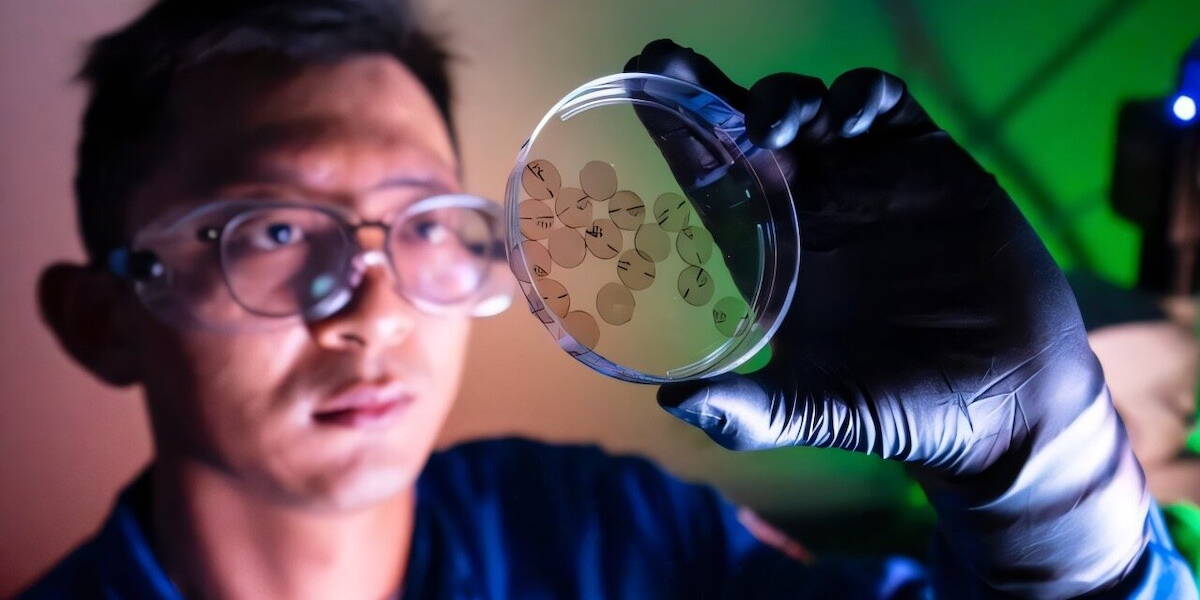

Onderzoekers van de University of California, Irvine hebben een innovatieve biohybride hartinterface ontwikkeld die met behulp van licht levende hartcellen kan aansturen. De technologie maakt het mogelijk om hartweefsel zowel elektrisch als mechanisch te stimuleren, zonder gebruik van traditionele metalen elektroden.
De resultaten van het onderzoek zijn gepubliceerd in Cell Biomaterials en markeren volgens de onderzoekers van UC-Irvine een belangrijke stap in de ontwikkeling van nieuwe onderzoeksmethoden en behandelopties voor hartziekten.
Licht als alternatief voor elektroden
De kern van de technologie is een meerlagig polymeermateriaal dat licht kan omzetten in elektrische signalen. Wanneer het materiaal wordt blootgesteld aan pulsen van zichtbaar groen licht, genereert het zogeheten fotostromen. Deze stimuleren hartcellen om synchroon samen te trekken, vergelijkbaar met een natuurlijke hartslag.
In tegenstelling tot conventionele stimulatietechnieken, die gebruikmaken van rigide metalen elektroden, is deze biohybride interface zacht en flexibel. Dat vermindert het risico op weefselschade en maakt langdurige toepassing in een biologische omgeving beter mogelijk. Bovendien sluit het materiaal beter aan bij het dynamische, continu bewegende karakter van het hart.
Realistisch model voor hartonderzoek
Voor de ontwikkeling van het systeem werden hartcellen van ratten gekweekt op het opto-elektronische substraat. Deze cellen werden georganiseerd in een structuur die lijkt op de vezelarchitectuur van menselijk hartweefsel. Door de constructie in een dunne, buigzame vorm te gieten, konden onderzoekers zowel de elektrische stimulatie als de mechanische respons van het weefsel nauwkeurig meten.
Een belangrijk verschil met bestaande technieken, zoals optogenetica, is dat deze methode geen genetische modificatie van cellen vereist. Dat maakt de technologie breder inzetbaar, ook voor onderzoek met niet-aangepast, menselijk weefsel.
Kansen voor medicijnontwikkeling
De onderzoekers zien belangrijke toepassingen in geneesmiddelenonderzoek en de studie naar hartziekten. In huidige laboratoriummodellen worden vaak elektroden gebruikt om hartweefsel te stimuleren, wat kan leiden tot meetfouten of verstoring van het biologische systeem. Alternatieve modellen missen vaak de complexiteit van echte hartweefselinteracties.
Met deze biohybride interface kunnen onderzoekers medicijnen direct testen op levend, lichtgestuurd hartweefsel en tegelijkertijd meerdere parameters analyseren. Denk aan elektrische respons, contractiekracht en structurele veranderingen in cellen. Dit biedt een completer en realistischer beeld van hoe geneesmiddelen het hart beïnvloeden.
Klinische mogelijkheden
Naast toepassingen in het lab kijken de onderzoekers ook naar klinische mogelijkheden. Zo zou de technologie in de toekomst kunnen worden ingezet als implanteerbare ‘hartpleister’ die beschadigd hartweefsel ondersteunt met gerichte, lichtgestuurde stimulatie.
Omdat het systeem flexibel is en geen metalen componenten bevat, lijkt het beter geschikt voor integratie in het lichaam dan bestaande pacemakertechnologieën. Wel zijn verdere ontwikkelingen nodig, bijvoorbeeld om het systeem te laten werken met lichtgolven die dieper in het weefsel kunnen doordringen, zoals nabij-infrarood.
Volgens de onderzoekers biedt deze technologie een nieuw platform waarin biologie, materiaalkunde en opto-elektronica samenkomen. Daarmee kan het bijdragen aan zowel fundamenteel onderzoek als de ontwikkeling van nieuwe, minder invasieve behandelstrategieën voor hartpatiënten.
Nieuwe pacemakertechniek
Vorig jaar presenteerden cardiologen van het HagaZiekenhuis een nieuwe techniek voor pacemakerimplantatie. Via een live-demonstratie tijdens het European Heart Rhythm Association-congres werd getoond hoe een pacemaker via de halsader wordt geplaatst, in plaats van de traditionele liesader.
De methode, die zes jaar geleden voor het eerst in Europa werd toegepast, trekt al geruime tijd internationale belangstelling. Het HagaZiekenhuis verzorgt samen met de Universiteit van Zürich trainingen voor cardiologen om de techniek aan te leren. Volgens de betrokken artsen biedt de aanpak voordelen voor patiënten: minder pijn, een kleinere kans op complicaties en een sneller herstel. Daarnaast is de route via de hals korter, wat de ingreep eenvoudiger maakt. De techniek wordt gezien als een patiëntvriendelijke innovatie binnen de hartzorg.